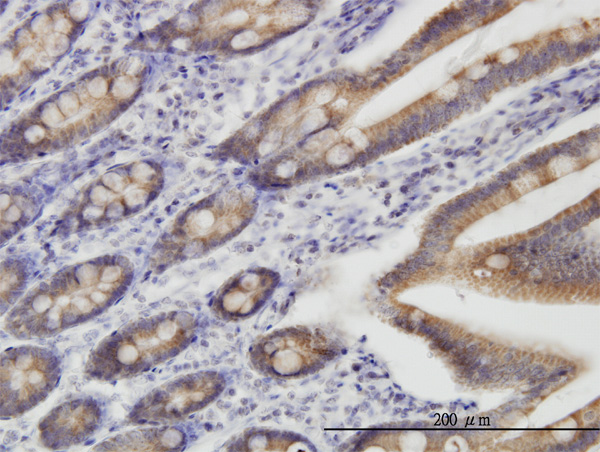

TOMM22 Antibody (monoclonal) (M01)
Mouse monoclonal antibody raised against a full length recombinant TOMM22.
- SPECIFICATION
- CITATIONS
- PROTOCOLS
- BACKGROUND

Application
| WB, IHC, IF, E |
|---|---|
| Primary Accession | Q9NS69 |
| Other Accession | BC009363 |
| Reactivity | Human, Mouse, Rat |
| Host | mouse |
| Clonality | Monoclonal |
| Isotype | IgG2a Kappa |
| Clone Names | 4G4 |
| Calculated MW | 15522 Da |
| Gene ID | 56993 |
|---|---|
| Other Names | Mitochondrial import receptor subunit TOM22 homolog, hTom22, 1C9-2, Translocase of outer membrane 22 kDa subunit homolog, TOMM22, TOM22 |
| Target/Specificity | TOMM22 (AAH09363, 1 a.a. ~ 142 a.a) full-length recombinant protein with GST tag. MW of the GST tag alone is 26 KDa. |
| Dilution | WB~~1:500~1000 IHC~~1:100~500 IF~~1:50~200 E~~N/A |
| Format | Clear, colorless solution in phosphate buffered saline, pH 7.2 . |
| Storage | Store at -20°C or lower. Aliquot to avoid repeated freezing and thawing. |
| Precautions | TOMM22 Antibody (monoclonal) (M01) is for research use only and not for use in diagnostic or therapeutic procedures. |

Thousands of laboratories across the world have published research that depended on the performance of antibodies from Abcepta to advance their research. Check out links to articles that cite our products in major peer-reviewed journals, organized by research category.
info@abcepta.com, and receive a free "I Love Antibodies" mug.
Provided below are standard protocols that you may find useful for product applications.
Background
The protein encoded by this gene is an integral membrane protein of the mitochondrial outer membrane. The encoded protein interacts with TOMM20 and TOMM40, and forms a complex with several other proteins to import cytosolic preproteins into the mitochondrion.
References
Toward a confocal subcellular atlas of the human proteome. Barbe L, et al. Mol Cell Proteomics, 2008 Mar. PMID 18029348.The mitochondrial TOM complex is required for tBid/Bax-induced cytochrome c release. Ott M, et al. J Biol Chem, 2007 Sep 21. PMID 17635912.TOM22, a core component of the mitochondria outer membrane protein translocation pore, is a mitochondrial receptor for the proapoptotic protein Bax. Bellot G, et al. Cell Death Differ, 2007 Apr. PMID 17096026.Global, in vivo, and site-specific phosphorylation dynamics in signaling networks. Olsen JV, et al. Cell, 2006 Nov 3. PMID 17081983.Identification of intrahepatic cholangiocarcinoma related genes by comparison with normal liver tissues using expressed sequence tags. Wang AG, et al. Biochem Biophys Res Commun, 2006 Jul 7. PMID 16712791.
If you have used an Abcepta product and would like to share how it has performed, please click on the "Submit Review" button and provide the requested information. Our staff will examine and post your review and contact you if needed.
If you have any additional inquiries please email technical services at tech@abcepta.com.





Foundational characteristics of cancer include proliferation, angiogenesis, migration, evasion of apoptosis, and cellular immortality. Find key markers for these cellular processes and antibodies to detect them.
The SUMOplot™ Analysis Program predicts and scores sumoylation sites in your protein. SUMOylation is a post-translational modification involved in various cellular processes, such as nuclear-cytosolic transport, transcriptional regulation, apoptosis, protein stability, response to stress, and progression through the cell cycle.
The Autophagy Receptor Motif Plotter predicts and scores autophagy receptor binding sites in your protein. Identifying proteins connected to this pathway is critical to understanding the role of autophagy in physiological as well as pathological processes such as development, differentiation, neurodegenerative diseases, stress, infection, and cancer.